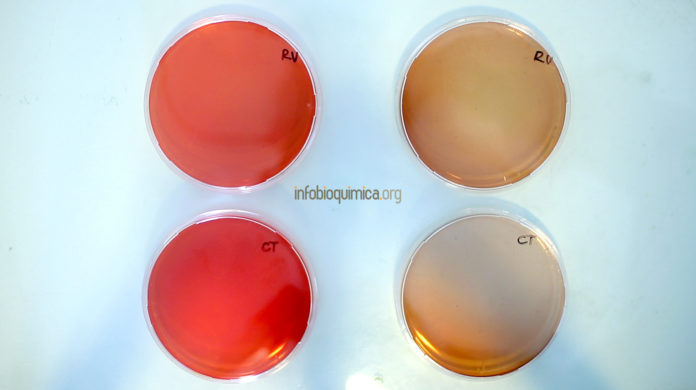

Neisseria meningitidis
Neisseria meningitidis puede causar meningitis invasiva, pero cada vez más es señalada como la causante de infecciones urogenitales. De hecho, un llamativo estudio de la década de 1970 describió cómo un chimpancé macho contrajo una infección uretral después de pasar la bacteria de su nariz y garganta a su propio pene, a través de la autofelación (un comportamiento habitual en estos animales).
Aproximadamente entre 5 y 10% de los humanos adultos también portan N. meningitidis en la parte posterior de su nariz y garganta. Los estudios sugieren que pueden potencialmente transmitir la bacteria a sus parejas a través del sexo oral, los besos profundos u otros tipos de contactos íntimos.
Los investigadores aún no están seguros de cuál de estas rutas de transmisión ha causado brotes de formas invasivas de la enfermedad entre hombres que practican sexo con hombres (HSH) en Europa, Canadá y Estados Unidos.
Sin embargo, otro estudio sobre la uretritis causada por N. meningitidis en hombres descubrió que la fuente de contagio fue el sexo oral. Los científicos determinaron que una cepa que afectó a varias ciudades de Estados Unidos en 2015 adquirió ADN mediante una recombinación genética con su pariente cercano, N. gonorrhoeae, que causa la gonorrea.
Esta mutación permitió que la ITS se propagara de forma más eficiente. Cinco tipos de N. meningitidis son responsables de la mayoría de las infecciones en todo el mundo. Afortunadamente existen dos vacunas que, combinadas, pueden ofrecer cierta protección.
Mycoplasma genitalium
Mycoplasma genitalium, una de las bacterias más pequeñas que se conocen, está ganando una reputación enorme como una ITS preocupante.
Identificada en la década de 1980, la bacteria hoy en día infecta aproximadamente a entre 1 y 2% de las personas, y es especialmente común en adolescentes y adultos jóvenes.
La infección por M. genitalium, aunque a menudo no presenta síntomas, puede imitar a una clamidiosis o una gonorrea, con irritación persistente de la uretra y el cuello uterino. Debido a que puede desencadenar una enfermedad inflamatoria pélvica en el sistema reproductor femenino, se ha asociado con infertilidad, aborto espontáneo, parto prematuro e incluso con muerte fetal.
Los preservativos pueden ayudar a prevenir la infección. En tanto, los investigadores han advertido sobre la creciente resistencia de M. genitalium al tratamiento con los antibióticos azitromicina y doxiciclina. “Mi preocupación sobre este microorganismo es que, a medida que se vuelva más resistente, será cada vez más prevalente”, dijo Matthew Golden, director del Programa de VIH/ITS de Salud Pública de Seattle y King County, Estados
Unidos.
Más pruebas podrían ayudar a prevenir la aparición de una superbacteria M. genitalium.
Sin embargo, los métodos de diagnóstico ya disponibles, basados en pruebas de orina e hisopados cervicales y vaginales, todavía se usan de forma muy infrecuente y en Estados Unidos aún no han sido aprobados por los organismos reguladores.
Shigella flexneri
La shigelosis se transmite por contacto directo o indirecto con las heces humanas. La infección causa calambres estomacales severos y brotes explosivos de diarrea llena de sangre y mucosidad, que ayudan a perpetuar la transmisión de la bacteria.
Aunque la enfermedad se asocia más comúnmente con niños pequeños y con personas que viajan por algunos países de ingresos bajos y medios, los científicos comenzaron a documentar casos de shigelosis en HSH en la década de 1970.
Los científicos creen que S. flexneri básicamente se aprovechó de un nuevo nicho para la transmisión a través del sexo anal-oral y, desde entonces, ha dado lugar a múltiples brotes en todo el mundo.
Demetre Daskalakis, subcomisionada del departamento de Salud e Higiene Mental de la ciudad de New York, dijo que esta ITS se está volviendo rápidamente resistente a la azitromicina, que también se usa para tratar la gonorrea. Señaló que, debido a que las agencias de salud pública están preocupadas por el potencial de la shigelosis para
impulsar el surgimiento de una superbacteria de gonorrea, muchos han adoptado una estrategia de tratamiento matizado.
Para los adultos que no tienen otros problemas de salud, los expertos ahora recomiendan no tomar antibióticos y dejar que la shigelosis siga su curso desagradable, pero generalmente limitado.
Linfogranuloma venéreo
Esta ITS, causada por cepas inusuales de Chlamydia trachomatis, puede provocar una “infección terrible”, según Christopher Schiessl, un médico de la clínica One Medical en el vecindario de Castro, en San Francisco.
El linfogranuloma venéreo (LGV) puede empezar produciendo un grano, ampolla o úlcera genital temporal y luego invadir el sistema linfático del cuerpo. La infección rectal puede simular una enfermedad intestinal inflamatoria y ocasionar anomalías crónicas y graves del colon y del recto, como fístulas y contracciones.
Durante la última década, el LGV se ha vuelto cada vez más común en Europa y América del Norte, y se ha asociado con múltiples brotes de enfermedades, especialmente entre HSH.
Al igual que con la clamidia, el LGV puede aumentar el riesgo de contraer el VIH. El uso de condones durante el sexo vaginal o anal puede reducir el riesgo de infección, mientras que tratar el LGV puede requerir un curso de antibióticos, como la doxiciclina, durante tres semanas.
Fuente: REC